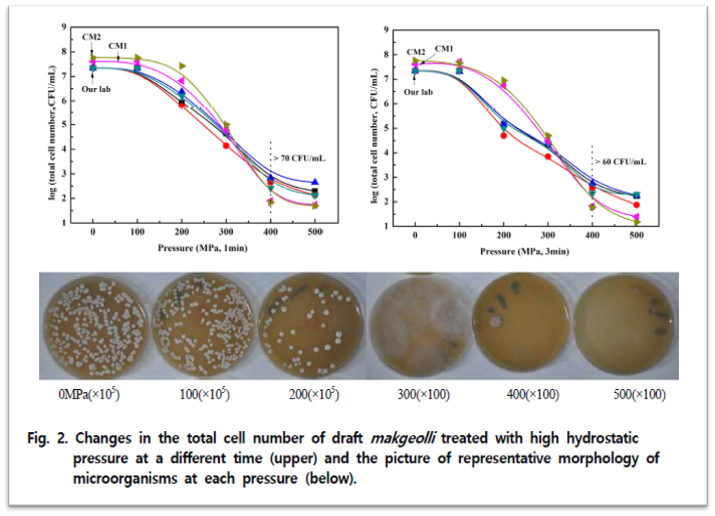

안녕하세요.
We Make Your Idea Possible! 일신오토클레이브입니다.
7월 들어 전국적으로 높은 기온과 장마로 인해 말 그대로 찜통인 날씨가 이어지고 있어요🫠. 특히 갑작스럽게 내리는 비가 잦아진것 같습니다. 이렇게 '비오는 날🌧️'하면 여러분은 무엇이 가장 먼저 떠오르시나요?
여러가지가 있겠지만 그 중에서도 "파전에 막걸리 한잔 하고싶다~" 하시는 분들도 꽤 많을것 같은데요😁, 오늘 소개해드릴 연구도 바로 그 막걸리와 관련된 내용이랍니다! 제조 특성상 유통기한이 짧은 편인 생막걸리에 초고압 처리를 적용해 유통기한을 연장해보고자 하는 것인데 과연 효과적이었을까요? 같이 보시죠!

막걸리는 전통지식과 기술계승의 의미를 가지고 있으며 체험적 요소가 있으므로 지역산업으로써 충분한 가치를 내포하고 있다. (중략) 그러나 생막걸리는 살균처리를 하지 않기 때문에 유통과정 중에도 발효가 일어난다. 때문에 유통 중에 알코올 함량이 지속적으로 상승하고 이산화탄소 발생으로 막걸리가 병 밖으로 새어나오게 된다. 맛 적인 측면에서도 미생물이 발효성 당을 소비하면서 단맛이 감소하게 되고 유산균이 증식하여 신맛이 증가하게 된다.
초고압 처리기술은 열을 사용하지 않고 미생물 살균, 단백질 변성, 효소 불활성화, 겔 형성 등의 작용을 하므로 식품에서 새로운 기술로 인식되고 있다. 특히, 저분자량 물질보다는 소수성 결합 등으로 이루어진 거대분자에 대하여 선택적으로 작용하므로, 천연의 향과 맛을 손상시키지 않으면서 미생물을 살균하거나 효소를 불활성화 시킬 수 있다.

미생물 제어 - UV조사
UV는 막걸리의 지방산 및 색소성분 등의 산화를 유도하여 산패취를 발생시키거나 변색을 유도할 가능성이 있다. 따라서 짧은 시간내에 처리되어야 하나 조사 60분까지 미생물 감소 효과가 없어 UV조사를 통한 막걸리 저장성 증진은 기대하기 어려울 것으로 판단되었다.
미생물 제어 - 초고압 처리
초고압 처리에 따른 막걸리의 생균수의 변화를 Fig. 2에 나타내었다. 시판 막걸리와 실험실에서 제조한 모든 막걸리에서 미생물이 지수적으로 감소되었다. (중략) 특히, 300MPa 이상의 압력에서는 대부분의 효모가 사멸되었으며, 400 MPa이상에서는 살아있는 효모가 관찰되지 않았다. 그러나 동일 압력에서 처리시간을 1분에서 3분으로 늘려보아도 생균수의 변화는 관찰되지 않아 막걸리의 미생물 제어는 처리시간보다 처리압력에 의존적인 것으로 확인되었다. (중략)
400과 500MPa의 압력으로 처리한 막걸리는 상온(25℃)에서 30일간 저장하여도 균체수가 증가하지 않았고 알코올, 산도, 아미노산도의 변화도 억제되었다. 그러나 30일 이상 상온에서 저장하면 막걸리의 산도와 아미노산도가 증가하면서 음용이 어려웠다. 저온(4℃)저장에서는 저장 70일까지 막걸리의 품질변화를 억제시켜 신선한 막걸리와 유사한 맛을 가지고 있었다.
[논문]초고압처리가 생막걸리의 저장기간 연장에 미치는 영향
생막걸리의 유통기간은 연장하고자 UV조사와 초고압처리를 하였다. UV조사는 막걸리내 미생물을 감소시키지 못하였으나 초고압처리는 급격하게 감소시켰다. 막걸리의 생균수는 2.2-5.8 × 107 CFU/mL
scienceon.kisti.re.kr
위에서도 언급되었듯이 살균처리를 하지 않는 생막걸리의 경우 유통기한이 짧을 수 밖에 없는데요, 이러한 생막걸리의 유통기한 연장은 제조자의 재고부담을 덜고 더 광범위한 유통범위 확장을 위한 돌파구가 될 수 있을거에요.
특히 요즘에는 환경적 이슈 등으로 식품업계 곳곳에서 유통기한을 연장시키고자 노력하고 있죠. 그런 상황에서 초고압 처리는 식품 본연의 맛과 향을 저해하지 않고 효과적으로 미생물을 사멸시키는 살균법으로써 주목받아 왔어요.
그리고 초고압 살균의 장점 하나더! 바로 식품의 포장상태에서 처리가 가능하다는 것이죠. 위의 연구에서도 초고압처리 결과, 상용 막걸리 PET병과 polyethylene 필름의 파손이나 용기의 변형이 없어 상용 막걸리 PET병을 사용하여도 초고압 처리가 가능한 것으로 나타났다고 해요! 그렇다면 기존의 가열살균 방식에 비해 용기 재질을 선택함에 있어서도 제한이 비교적 적겠죠?

저희 일신오토클레이브에서는 초고압 살균 장비인 HPP(High Pressure Processing)를 다양한 용량에 맞추어 설계 및 제작하고 있습니다. 여기서 끝이 아니죠! 당장 장비를 도입하기엔 부담이 되거나 장비 운용에 따르는 유지보수 비용 등으로부터 자유롭고 싶은 분들을 위해 HPP Tolling Center도 운영중이랍니다!
아래의 공식 홈페이지 링크에서 더욱 자세한 내용을 보실 수 있으니 참고하시고 문의사항은 일신오토클레이브 대표번호(042-931-6100)로 편하게 연락주세요!
📢일신오토클레이브의 HPP(High Pressure Processing) 장비 보러가기!📢
HiPPo
비가열고압살균, 초고압살균, 초고압살균공정,.유통기한연장, 초고압처리, HPP
hpp.co.kr
📢일신오토클레이브의 HPP Tolling Center 구경하기!📢
소재부품장비 글로벌 강소기업 | 일신오토클레이브
고온고압 장비 전문, Autoclave, 고압반응기, 초임계, 압력용기, 초고압분산기, 항온가압챔버 제조
www.suflux.com
| [관련동향] 사용후핵연료의 처분 - 한국형 솔루션을 찾아서 (0) | 2024.08.08 |
|---|---|
| [일신기술] 초고압의 활용 - 강황 잎 추출물의 피부 면역 활성효과 (0) | 2024.08.01 |
| [일신기술] 초고압 추출 | 초고압 처리가 블루베리의 항산화 증진에 미치는 영향 (3) | 2024.07.22 |
| [관련동향] 플라스틱의 화학적 재활용 - 초임계 열분해 기술로 알아보자! (0) | 2024.06.28 |
| [관련동향] 배터리뉴스 (3) - 리튬이차전지의 수명을 3배 UP! 새로운 복합소재의 개발 (1) | 2024.06.13 |